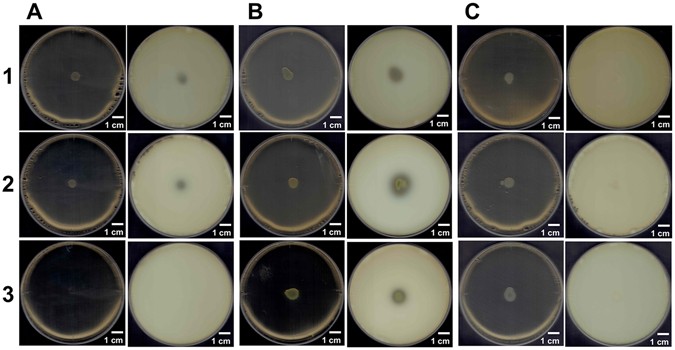
Figure 3

Figure 3
From: A bacterial ABC transporter enables import of mammalian host glycosaminoglycans
Degradation of GAGs. (A) S. moniliformis. (B) P. heparinus as a positive control. (C) E. coli as a negative control. Plates on the left and right represent before and after addition of acetic acid, respectively. Plates 1, 2, and 3 contained hyaluronan, chondroitin sulfate C, and heparin, respectively.